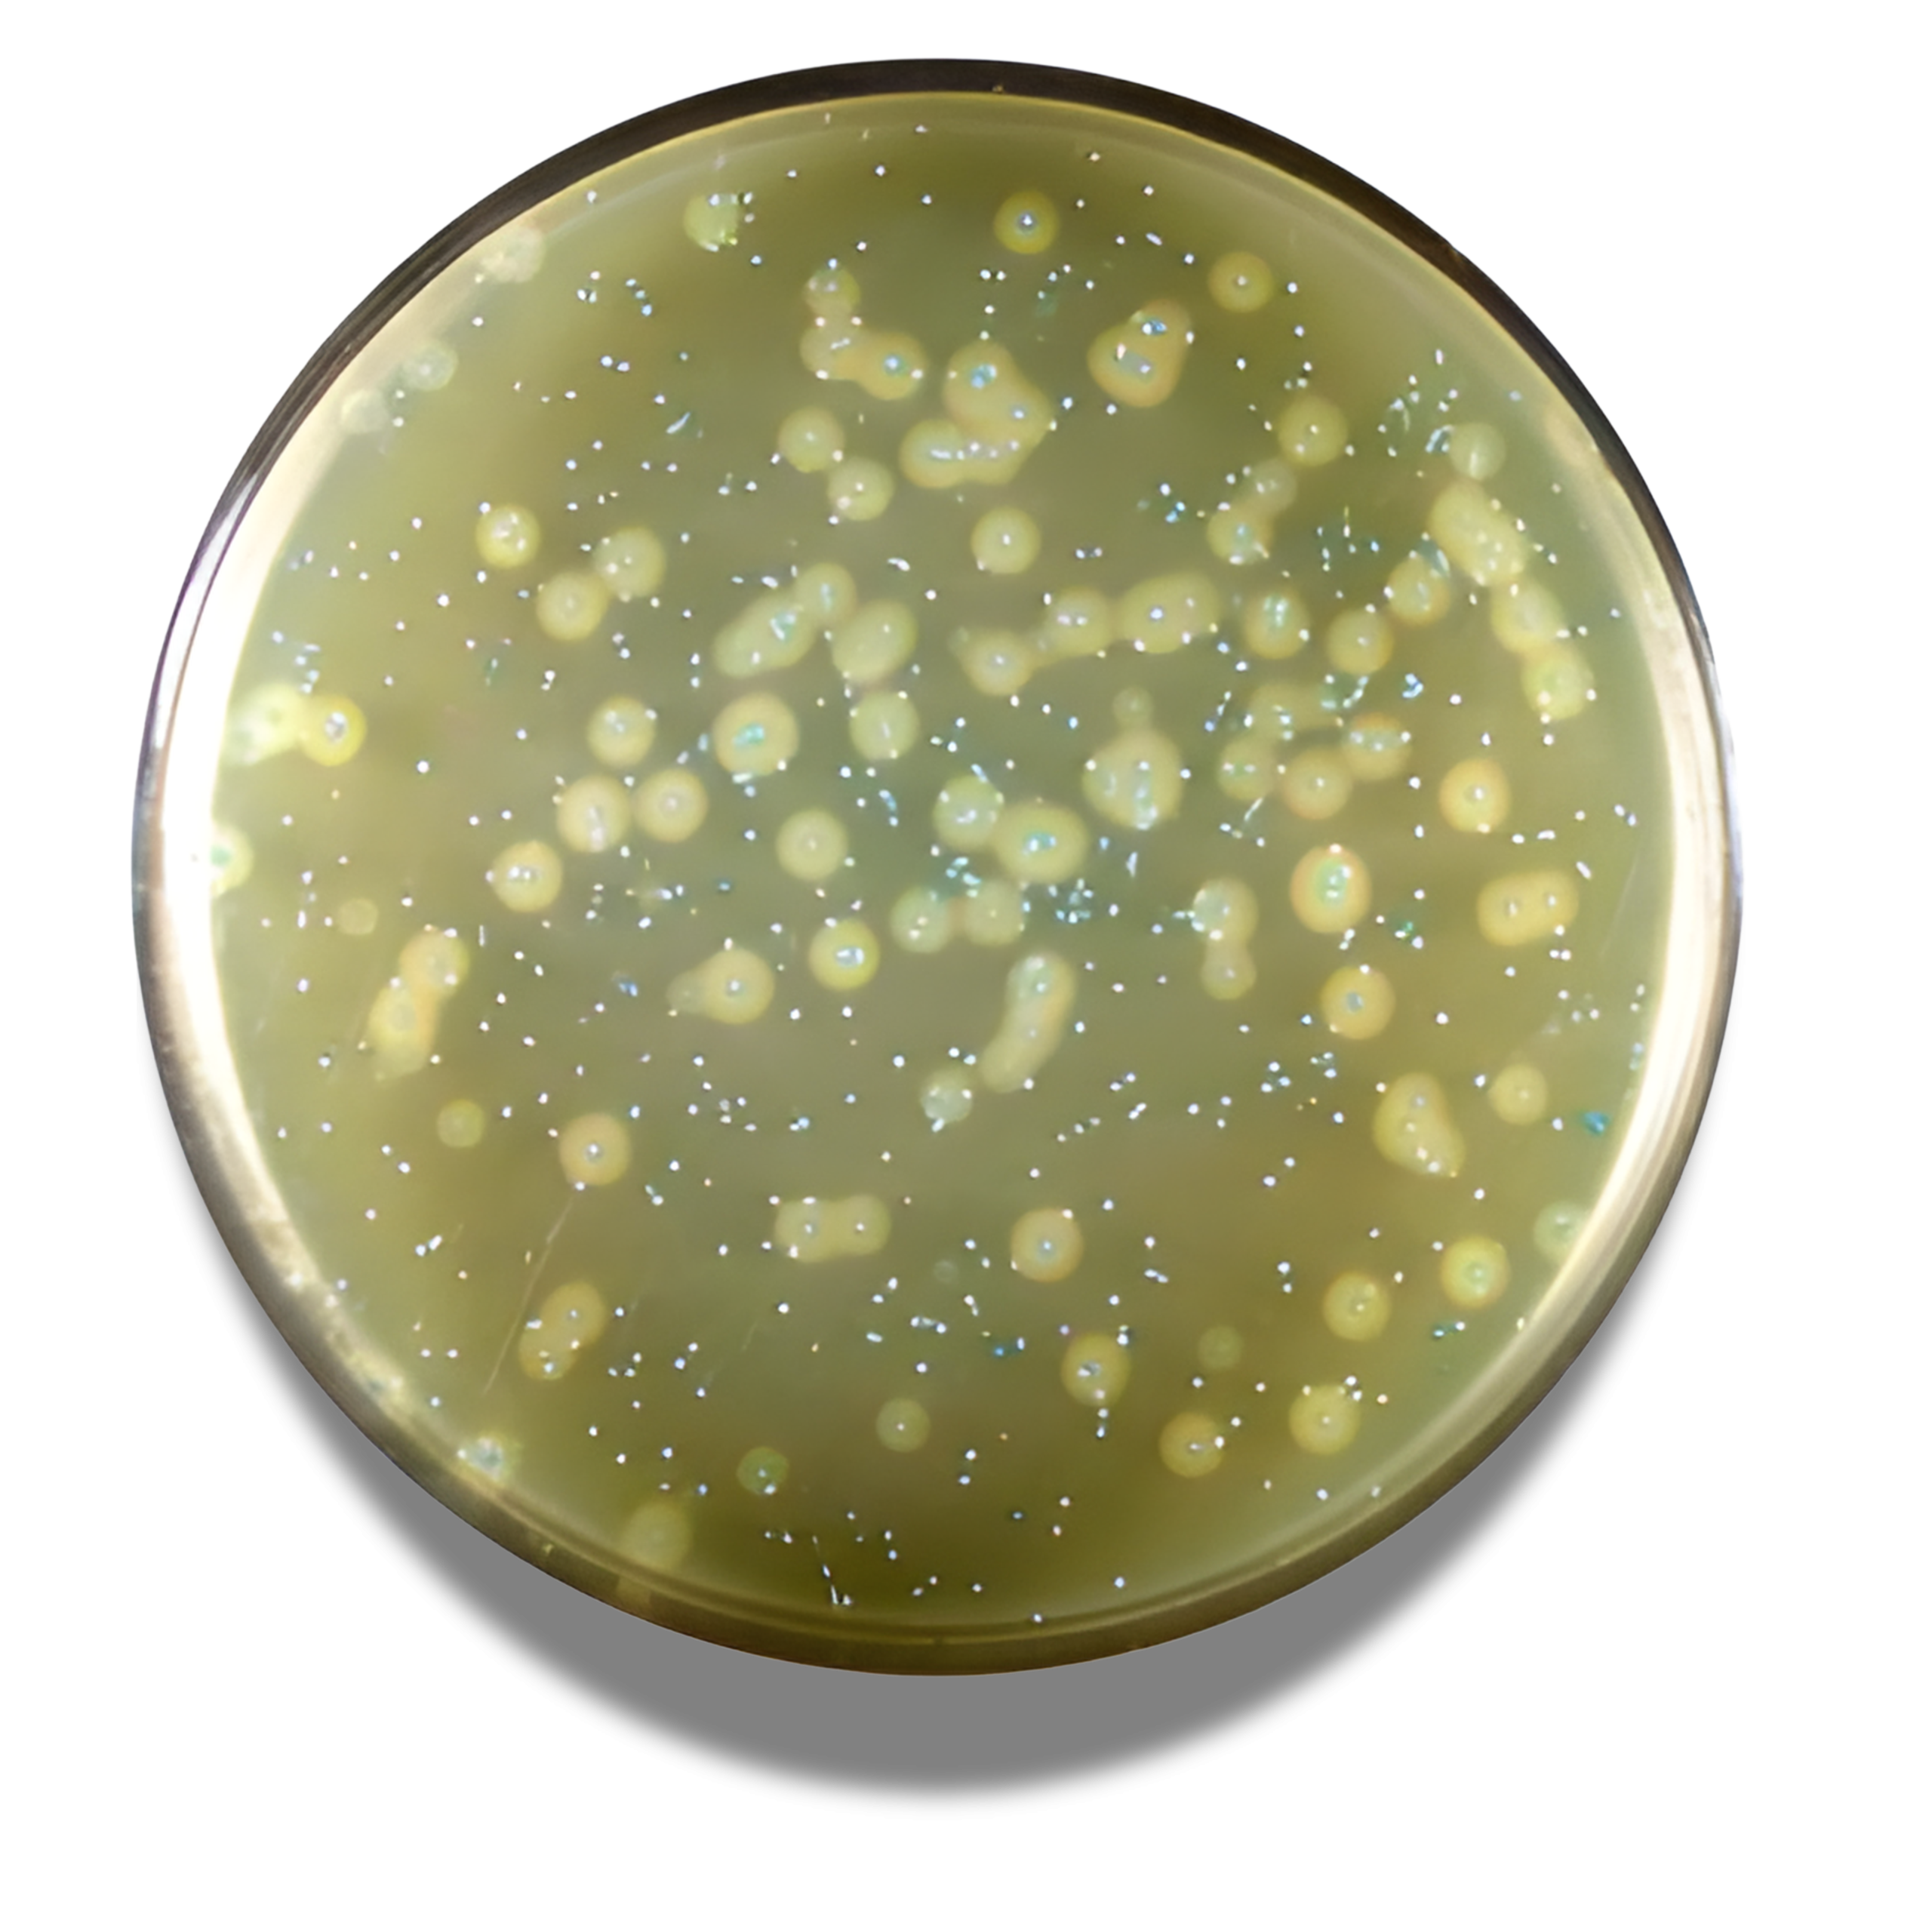

- Wishlist
- SKU : 4016052
- 500 g
Additional Info
| Brand |
BioLife |
|---|
For the detection and enumeration of Listeria monocytogenes and Listeria spp. in samples of the food chain and in environmental samples.
Be the first to review “AGAR LISTERIA ACC. TO OTTAVIANI AND AGOSTI (ALOA)” Cancel reply
You must be logged in to post a review.
Reviews
There are no reviews yet.